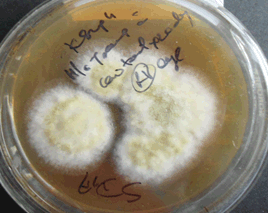

Context: Ophthalmic morbidities pose a huge burden to society as well as individuals. In India the projected prevalence of blindness as per (2015-2018) survey from NPCB is 0.45 %, of which corneal blindness constitute 0.9% causes. Microbial keratitis is an important cause attributing to avoidable cause of corneal blindness.
Aims: To determine the aetiopathogenesis and antimicrobial susceptibility pattern among the isolates causing microbial keratitis.
Settings and design: It were a prospective study carried out from June 2014 to April 2019.
Methods and Material: Corneal scrap, vitreous, anterior chamber tap, conjunctival swab and corneal button samples of all the patients suspected of microbial keratitis were subjected to direct microscopy (gram’s stain and 10% KOH mount) and culture on blood agar and sabouraud’s dextrose agar. The isolates were identified and drug susceptibility testing was performed as per CLSI M51-A for four drugs Voriconazole, Amphotericin B, Fluconazole and Itraconazole.
Results: Out of 267 cases of corneal ulcers 50 (18.7%) were bacterial causes, 147(55) % were fungal isolates among which 93.8% revealed fungal hyphae in 10% KOH wet mount and rest showed no hyphae on direct examination but were culture positive,4 cases of Acanthamoeba spp and 3 cases of Microsporidium spp were identified. In 40 cases no growth either bacterial or fungal was observed. Aspergillus spp (72%) and Fusarium spp (29%) were the predominant isolates among fungal corneal ulcers and Staphylococcus aureus (36%), Pseudomonas aeruginosa (24%) and Streptococcus species (18%) were the predominant isolates among bacterial corneal ulcers.
Conclusion: Microbial keratitis is an important cause of corneal blindness. Fungal etiology is more common to cause keratitis specially in agriculture dominated region like ours because of trauma due to vegetative matter.
Ophthalmic morbidities pose a huge burden to society as well as individuals. According to reports from WHO, globally the number of people of all ages visually impaired is estimated to be 1.3 billion of whom 36 million are blind [1]. In India the projected prevalence of blindness as per (2015-2018) survey from NPCB is 0.45 %. These days corneal diseases are among the major causes of vision loss and blindness in the world, after cataract and glaucoma [2]. In India corneal blindness constitute 0.9% of all the causes of blindness. Cornea is usually protected from anatomical and physiological barriers like blinking of eyelids, tight junction present at corneal epithelial cells and substances like lactoferrin, lysozyme, antimicrobial peptides, antibodies, and bacteriocins which inhibit the growth of microbes [3]. Whenever these barriers get compromised infection may occur which leads to inflammation, ulcers and if not treated timely it may lead to loss of vision [4]. Trauma, systemic illnesses like diabetes mellitus, long term use of topical corticosteroids, presence of ocular surface diseases, long term use of contact lens, ocular surgery, are the most common predisposing factors [5]. In India studies highlight that cause of most of the cases of microbial keratitis is attributed to trauma and is more common in men in agricultural occupation [6].
This 5-year study was taken to assess the epidemiology of microbial keratitis, its diagnosis and antimicrobial susceptibility pattern among isolates of community associated corneal ulcer in North eastern part of Uttar Pradesh.
This study was conducted in a tertiary care institute of North Eastern part of Uttar Pradesh from June 2014 to April 2019 .Samples like corneal scrap, vitreous, anterior chamber tap, conjunctival swab and corneal button, samples of all the patients suspected of microbial keratitis were inoculated directly on blood agar and Sabouraud’s dextrose agar plates and simultaneously 2 smears were prepared for gram’s staining and 10% KOH mount. Growth was considered to be positive only when both the culture plates showed growth of same organisms. All the isolates were identified using standard methodologies and antimicrobial susceptibility testing was also done using disc diffusion methods per CLSI (S-100) for bacterial isolates and as per CLSI M51-A for four antifungal drugs i.e. Voriconazole, Amphotericin B, Fluconazole and Itraconazole for fungal isolates.
In the study period a total of 267 samples were received in microbiology laboratory, out of which 204(76.4% out of 267 samples) cases were confirmed to be positive by culture for bacterial, fungal and mixed etiologies. (figure1,2,3) Forty cases were negative by culture or direct microscopy. Among 204 culture positive cases, 50 (24% out of 204) were bacterial isolates, (Table 1) 147(72%) (Table 2) were fungal isolates. Among the fungal isolates 93.8% (139) revealed fungal hyphae in 10% KOH wet mount and rest showed no hyphae on direct examination but were culture positive. There were two cases which were confirmed to be have mixed etiologies. (Table 3) One isolate was Candida albicans, 4 cases were Acanthamoebas spp and 3 cases Microsporidium spp (Figure 4 &5) were identified. Aspergillus spp (73%) and Fusarium spp (43%) were the predominant isolates among fungal corneal ulcers and Staphylococcus aureus (36%), Pseudomonas aeruginosa (24%) and Streptococcus species (18%) were the predominant isolates among bacterial corneal ulcers. All the cases were in the age group 3-70 years. Keratitis due to bacterial and fungal pathogens showed male preponderance (54% out of 43) and (55% out of 73) respectively and most of them were in age group in 31-40 years. Among 73 isolates of Aspergillus, Aspergillus flavus was the most common (68% out of 73). (Figure 6)

Figure 1. Fungal corneal ulcer

Figure 2.Corneal infiltrates caused by P.aeruginosa

Figure 3. Corneal infiltrates caused by C.albicans

Figure 4. Microsporidia spores on Gram’s stain (1000 x)

Figure 5. Microsporidia spores on modified trichrome stain (1000 x)

Figure 6. Aspergillus culture on SDA
Table 1. Bacterial isolates
S No |
Organism isolated |
Number |
1. |
Staphylococcus aureus |
18 |
2. |
Streptococcus pneumoniae |
9 |
3. |
Streptococcus spp |
2 |
4. |
CONS |
5 |
5. |
Pseudomonas aeruginosa |
12 |
6. |
Nocardia spp |
4 |
7. |
Total |
50 |
Table 2. Fungal isolates
S.NO |
Organism isolated |
Number |
1. |
Aspergillus flavus |
50 |
2. |
Aspergillus fumigatus |
3 |
3. |
Aspergillus terreus |
2 |
4 |
Aspergillus nidulans |
2 |
4. |
Aspergillus spp unidentified |
11 |
5. |
Fusarium spp. |
43 |
6. |
Unidentified Phaeoid fungi |
6 |
7. |
Penicillium spp |
2 |
8. |
Alternaria |
5 |
9. |
Acremonium |
5 |
10. |
Penicillium spp |
2 |
11. |
Scedosporium spp |
2 |
12. |
Syncephalastrum spp |
1 |
13. |
Bipolaris |
2 |
14. |
Colletotrichum |
1 |
15. |
Curvularia |
4 |
16. |
Unidentified hyaline fungi |
5 |
17. |
Candida albicans |
1 |
18. |
Total |
147 |
Table 3. Mixed infections
|
S.no |
Organisms isolated |
|
|
1. |
Aspergillus spp + Pseudomonas aeruginosa |
1 |
|
2. |
Aspergillus flavus + Staphylococcus aureus |
1 |
In this study, 32 isolates of Aspergillus species and 25 isolates of Fusarium were subjected to antifungal drug susceptibility testing for four drugs by disk diffusion method. It was seen that among isolates of Aspergillus susceptibility to Voriconazole, fluconazole, itraconazole and Amphotericin B was found to be 97%, 44%, 28% and 50% respectively. Among Fusarium species antifungal susceptibility to Voriconazole, Itraconazole, fluconazole and Amphotericin B was 72%, 52%, 20% and 60% respectively. (Table 4)
Table 4. Antifungal susceptibility of fungal species isolated
S.no |
Antifungal agents |
Aspergillus spp (n=32) |
Fusarium spp (n=25) |
S |
R |
S |
R |
1. |
Voriconazole |
31(97%) |
1(3%) |
18(72%) |
7(28%) |
2. |
Itraconazole |
23(72%) |
9(28%) |
13(52%) |
12(48%) |
3. |
Fluconazole |
18(56%) |
14(44%) |
5(20%) |
20(80%) |
4. |
Amphotericin B |
16(50%) |
16(50%) |
15(60%) |
10(40%) |
|
|
|
|
|
|
46 bacterial isolates were subjected to antibiotic sensitivity testing by standard method. (Table 5)
Table 5. Antifungal susceptibility of bacterial species isolated
S.no. |
Antimicrobial agents |
S.aureus (n=18) |
CONS(n=5) |
Streptococcus spp.(n=11) |
P.aeruginosa (n=12) |
S |
R |
S |
R |
S |
R |
S |
R |
1. |
Penicillin |
0 |
18 |
0 |
5 |
11 |
0 |
- |
- |
2. |
Cefoxitin |
10 |
0 |
3 |
2 |
- |
- |
- |
- |
3. |
Erythromycin |
6 |
12 |
2 |
3 |
8 |
3 |
- |
- |
4. |
Clindamycin |
6 |
12 |
4 |
1 |
8 |
3 |
- |
- |
5. |
Cotrimoxazole |
7 |
11 |
2 |
3 |
10 |
2 |
- |
- |
6. |
Vancomycin |
18 |
0 |
5 |
0 |
11 |
0 |
- |
- |
7. |
Linezolid |
18 |
0 |
5 |
0 |
11 |
0 |
- |
- |
8. |
Ciprofloxacin |
10 |
8 |
4 |
1 |
11 |
0 |
6 |
6 |
9. |
Netlimicin |
17 |
1 |
5 |
0 |
- |
- |
- |
- |
10. |
Moxifloxacin |
18 |
0 |
5 |
0 |
- |
- |
- |
- |
11. |
Gentamicin |
16 |
2 |
5 |
0 |
- |
- |
12 |
0 |
12. |
Piperacillin |
- |
- |
- |
- |
- |
- |
8 |
4 |
13. |
Ceftazidime |
- |
- |
- |
- |
- |
- |
10 |
2 |
14. |
Amikacin |
- |
- |
- |
- |
- |
- |
9 |
3 |
15. |
Levofloxacin |
- |
- |
- |
- |
- |
- |
6 |
6 |
16. |
Cefepime |
- |
- |
- |
- |
- |
- |
6 |
6 |
17. |
Imipenem |
- |
- |
- |
- |
- |
- |
8 |
4 |
18. |
Polymixin B |
- |
- |
- |
- |
- |
- |
12 |
0 |
Cefoxitin S: Methicillin Sensitive, Cefoxitin R: Methicillin Resistant
Ocular infections are an important cause leading to visual impairment. The ocular surface is constantly exposed to a large number of infectious agents; however, only a few pathogens can cause a corneal infection. Several mechanisms play a major role in the protection of the surface of the eye from infectious agents. In our study also most common risk factor associated with fungal keratitis is trauma with vegetative matter and most of the cases (60% of 147) were recorded in harvest season [7]. There has been an increase in ocular infections in recent times owing to weather conditions, prolonged screen timings and increased usage of ocular drugs [8]. There has been increase in incidence of fungal keratitis in tropical countries like India, as well as in western countries [9]. Chander et al reported Most common risk factors associated with fungal keratitis is trauma with vegetable matter, sand and metallic objects and most commonly cases of fungal keratitis are seen in harvest season [7]. Other risk factors found in our study were diabetes mellitus, use of steroids and ocular surgeries. Filamentous fungi are frequent causes of corneal ulcer in human [10,11]. It is caused by Aspergillus spp., Fusarium spp., Candida spp.Rhizopus, Mucor, and other fungi [11,12]. This study shows that Aspergillus flavus was the predominant species associated with ocular infection and account for 72% of all the fungal isolates isolated from ocular specimens followed by Fusarium species. Increased incidence was seen in the months of April to October. Fungal corneal ulcers may be reported at any age and in the present study, the age of the patients varied from 3 to 70 years. However, the most susceptible age group was 31 to 40 years. In addition, fungal corneal ulcers were found to be more common in men than in women. Corneal trauma has been identified as the most common risk factor for fungal keratitis, which was also the case in the present study [12]. Similar finding was also observed by Chidambaram et al, 2018 [13].
Trauma due to vegetative matter was reported to be the most frequent predisposing factor in this study. Aspergillus species were most commonly associated with fungal keratitis. Among Aspergillus, Aspergillus flavus was the commonest species involved followed by fusarium species. Identification of the fungal isolates to the species level and antifungal susceptibility testing against different drugs may be crucial in choosing the right drug.
- Blindness and vision impairment. [Crossref]
- National Programme for Control of Blindness and Visual Impairment (NPCB) last accessed on 2019 May 9. [Crossref]
- Zhou L, Zhao SZ, Koh SK, Chen L, Vaz C, et al. (2012) In-depth analysis of the human tear proteome. J Proteomics. 75:3877-3885. [Crossref]
- Ansari Z, Miller D, Galor A (2013) Current thoughts in fungal keratitis Diagnosis and treatment. Curr Fungal Infect Rep. 7:209-218. [Crossref]
- Wong RLM, Gangwani RA, Yu LWH, Lai JSM (2012) New treatments for bacterial keratitis. J Ophthalmol. 2012:831502. [Crossref]
- Gopinathan U, Sharma S, Garg P, Rao GN (2009) Review of epidemiological features, microbiological diagnosis and treatment outcome of microbial keratitis: experience of over a decade. Indian J Ophthalmol. 57:273-279. [Crossref]
- Chander J, Singla N, Agnihotri N, Arya SK, Deep A (2008) Keratomycosis in and around Chandigarh: A five‑year study from a north Indian tertiary care hospital. Indian J Pathol Microbiol. 51:304‑306. [Crossref]
- Acharya Y, Acharya B, Karki P (2017) Fungal keratitis: study of increasing trend and common determinants. Nepal J Epidemiol. 7:685-693. [Crossref]
- Ong HS, Fung SSM, Macleod D, Dart JKG, Tuft SJ, et al. (2016) Altered Patterns of Fungal Keratitis at a London Ophthalmic Referral Hospital: An Eight-Year Retrospective Observational Study. Am J Ophthalmol. 168:227-236. [Crossref]
- Binnani A, Gupta PS, Gupta A (2018) Epidemio-Clinico-Microbiological Study of Mycotic Keratitis in North-West Region of Rajasthan. Mycopathologia. 183:717-722. [Crossref]
- Thomas PA (2003) Fungal infection of the cornea. Eye. 17:852-862. [Crossref]
- Tilak R, Singh A, Maurya OP, Chandra A, Tilak V, et al. (2010) Mycotic keratitis in India: A five-year retrospective study. J Infect Dev Ctries. 4:171-174. [Crossref]
- Chidambaram JD, Venkatesh PN, Srikanthi P, Lanjewar S, Shah M, et al. (2018) Epidemiology, risk factors, and clinical outcomes in severe microbial keratitis in South India. Ophthalmic Epidemiol. 25:297-305. [Crossref]